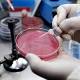
Caso di Tbc in scuola del Modenese - ANSA.it

ANSA.it | Caso di Tbc in scuola del Modenese ANSA.it (ANSA) - MODENA, 20 NOV - C'è un caso di Tbc polmonare in un giovane che frequenta un istituto superiore a Castelfranco Emilia, nel Modenese. Lo rende noto l'Ausl di Modena. Il paziente, attualmente ricoverato al Policlinico, è in buone condizioni e il ... Studente di Castelfranco malato di Tbc, scatta la profilassiIl Resto del Carlino (Blog) Caso di TBC polmonare a scuola, scattano i controlli e profilassiModenaToday Un caso di TBC polmonare in un Istituto Superiore di Castelfranco EmiliaSassuolo 2000 Gazzetta di Modena tutte le notizie (6) » |
